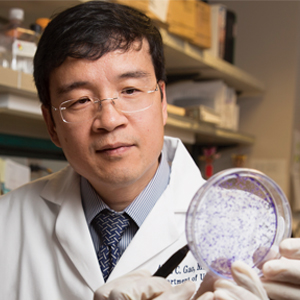
Allen Gao examines cultures in the research lab. (c) UC Regents

Research Overview
The Department of Urologic Surgery is dedicated to advancing the understanding, diagnosis and treatment of urological diseases through innovative research and clinical excellence. Our research experts seek to translate scientific discovery into improved patient outcomes.
As one of the nation’s largest and most comprehensive urologic research programs, our department includes six active laboratories supported by millions in competitive research funding. In fact, our department ranked among the top 10 in the 2022 and 2023 Blue Ridge Rankings for National Institutes of Health research funding.
We’re proud to be leading efforts to understand why some urologic cancers become resistant to treatment and to discover new therapies for advanced prostate cancer.
Basic and Translational Research
Our largest research program focuses on urologic oncology, particularly prostate and bladder cancer. Multiple investigators are studying the molecular pathways that drive disease progression, including mechanisms by which androgen receptors promote prostate cancer growth.
The department is also advancing discoveries in pediatric urology. Our researchers are exploring how adult and embryonic stem cells can be used to guide cell growth and repair damaged tissue. This important work may one day lead to new treatment options through tissue engineering and regenerative medicine.
Learn more about our faculty's basic and translational research »
Clinical Research
Urologic Oncology
Urologic oncology clinical trials are coordinated through the Comprehensive Cancer Center's Clinical Trials Support Unit and cover all aspects of urological cancer. Several laparoscopic procedures are being performed as part of clinical trials to evaluate their usefulness in treating urological diseases.
Endourology
Endourology clinical studies are looking at ways to prevent renal stone formation and to understand the pressure changes that occur during percutaneous stone removal.
Female Incontinence
The department has long been involved in clinical research on female incontinence. One of our recent studies compared the effectiveness of transvaginal tape (TVT) and traditional slings in treating female incontinence issues.
Pediatric Urology
Our pediatric urology research focuses on quality-of-life measures, clinical outcomes and the application of minimally invasive surgical approaches.
Male Infertility and Sexual Dysfunction
Our male infertility and sexual dysfunction research aims to provide a holistic, couple-centered approach to the treatment of sexual problems.
Residents’ Research Program
During their PGY5 year, all residents have four months dedicated to research. They may select a mentor, develop an independent project or join an existing study. The research rotation is designed to provide hands-on experience, foster critical evaluation of scientific literature and cultivate scholarly productivity. Historically, residents have produced four to 10 manuscripts during this time, an experience that contributes to the high rate of graduates securing competitive fellowship positions.

